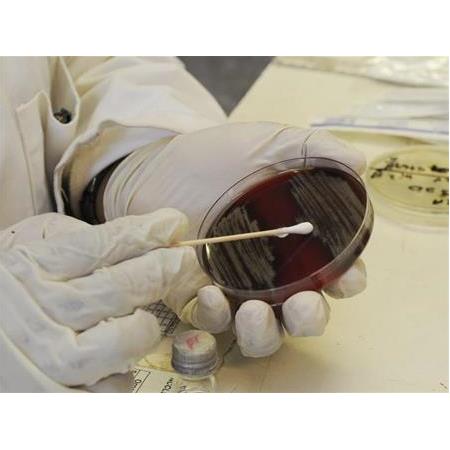
Tekstil Malzemelerinde Antibakteriyel Aktivite Tayinleri ASTM E 2149

Madenler ve Kullanım Alanları
Amonyak ve Kullanım Alanları
Mesh Mikron Tablosu
Akademik Araştırma Siteleri
Periyodik Tablo Elementler
Amonyum Klorür Nedir ? Kullanım Alanları.
Silisyum Karbür Nedir? Kullanım Alanları
Grafit Toz Nedir ? Grafit Kullanım Alanları
Fulleren Nedir? Kullanım Alanları
Grafen Oksit Nedir? Kullanım Alanları
Bize Ulaşın
-
Kurtköy Mah. Ankara Cad. Yelken Plaza No: 289/21 PENDİK / İSTANBUL
-
+90 216 526 04 90
-
+90 532 134 47 92
-
+90 216 212 01 21
-
+90 532 134 47 92
-
bilgi@nanokar.com.tr
E-Bülten Aboneliği
-
Kampanya ve yeniliklerden haberdar olmak için e-bültenimize kayıt olun.
KURUMSAL
SİPARİŞ

Eticaret Kur E-ticaret Altyapısıyla Hazırlanmıştır